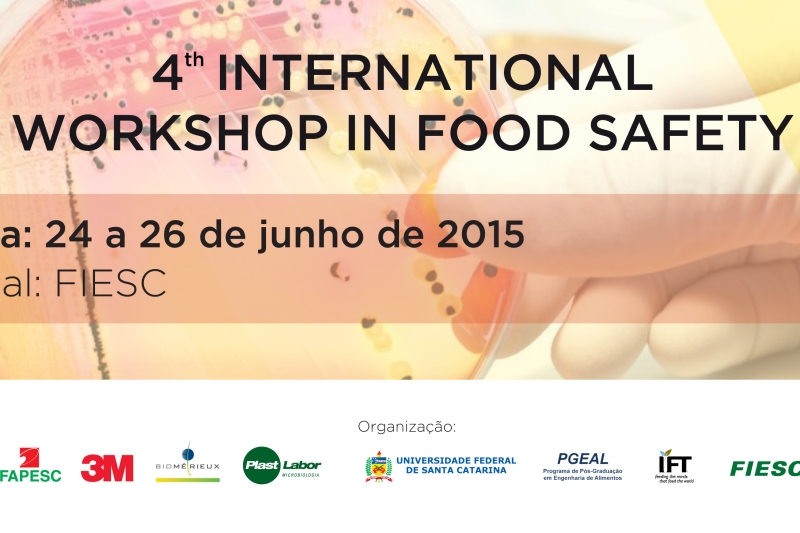

-

Educação
FIESC implanta em Jaraguá do Sul Câmara Regional do Movimento A Indústria pela Educação
-

Indústria catarinense projeta investimentos de R$ 4,4 bi até 2017
-
SENAI/SC promove cursos e workshop em segurança de alimentos
-

Apenas 90 indústrias de SC, entre 2,3 mil aptas, aderiram à Lei do Bem
-

SESI/SC realiza campeonato de tênis neste final de semana
-

Confiança do industrial catarinense cai em junho
-

Na segunda-feira, FIESC sediará seminário nacional sobre micro e pequenas
-

SC busca maior aproximação com a Holanda
-

Setor de papel e celulose aposta na sustentabilidade para seguir crescendo no Estado
-

Educação
Jovens abrigados no Alto Vale têm oportunidade de se qualificar para o mundo do trabalho




